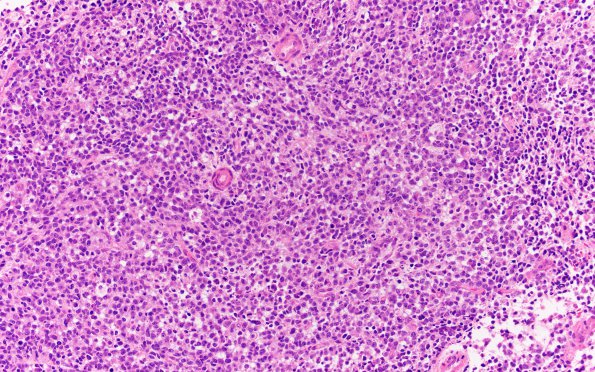
17B2 ATRT (Case 17) H&E 20X 2

Table of Contents
Washington University Experience | NEOPLASMS (EMBRYONAL) | ATRT - Atypical Teratoid Rhabdoid Tumor | 17B2 ATRT (Case 17) H&E 20X 2
Sections of the "posterior fossa tumor" show a diffusely infiltrating small round blue cell tumor with large nuclei, vesicular chromatin pattern and scant cytoplasm. Admixed nests of larger cells with moderate amounts of eosinophilic cytoplasm, vesicular nuclei with prominent nucleoli (rhabdoid cells) are noted. There is increased mitotic activity and abundant necrosis.